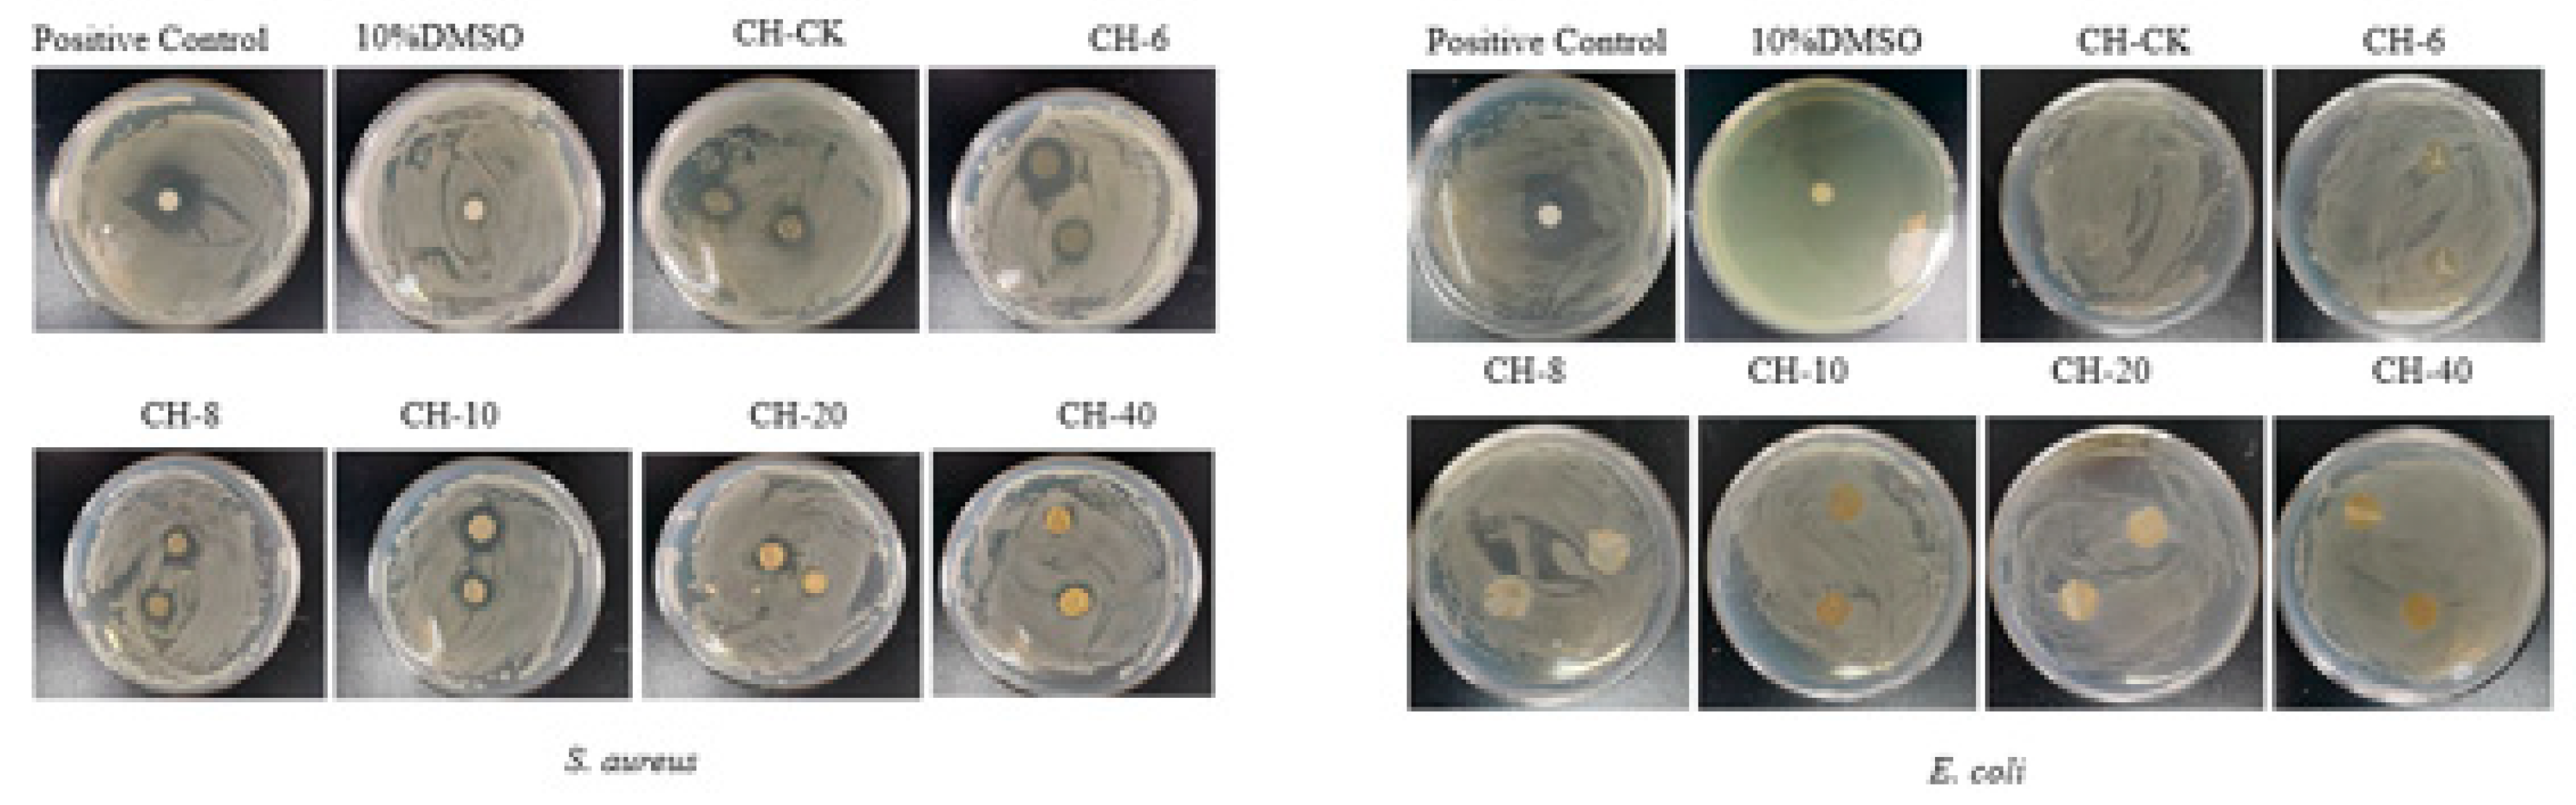
Preprints 101904 g005

1. Introduction
With the remarkable demand for fruits and vegetables, antibacterial packaging has been produced to control or inhibit microbial growth and keep food quality and safety. Existing oil based packaging materials cause serious environmental problems owing to their non-degradable properties, which will finally threaten the health of people [
1,
2]. In particular, the application of natural essential oils (EOs) as antimicrobial agents promisingly delays the growth of pathogenic microbes. Emerging studies has increased due to the potential of some active packaging to suppress food spoilage and extend shelf life, especially active packaging containing natural polymers with potent antioxidant and antibacterial properties [
3,
4]. The composite films can be fabricated from natural polymers such as chitosan, cellulose derivatives, collagen, elastin and starch and utilized as packaging materials to extend shelf life and product safety [
5]. Chitosan (CH) is a naturally abundant cationic polymer for antibacterial packaging to meet the growing needs of safe and biodegradable packaging [
6,
7]. Therefore, chitosan edible coatings and films incorporated with EOs have expanded the general applications of antimicrobial packaging in fruits and vegetables [
8].
Chitosan is a linear cationic polysaccharide consisting of d-glucosamine and n-acetyl-d-glucosamine monomer linked β-(1
→4), which is chemically composed of cellulose-based biopolymers derived by deacetylating chitin [
9]. CH is a natural biomaterial widely used in agriculture, food packaging, biomedical engineering and other fields because of its non-toxic, degradable, wide availability, reproducibility, good biocompatibility and strong film-forming ability [10-13]. Although CH has great potential as an antibacterial packaging material [
14], it still has disadvantages as a film and coating, such as insufficient UV, poor antioxidant and antimicrobial properties. And alone it has little effect on common strains of microorganisms that cause spoilage [
15]. To overcome these shortcomings, some researchers have combined chitosan films with natural compounds (e.g., plant EOs, organic acids, or fruit extracts) for the fabrication of antimicrobial biodegradable packaging in combination with film [16-18]. Furthermore, UV exposure accelerates the aging and degradation of these films and thus significantly reduces their lifetime [
19]. Common physical UV-shielding products suffer from various drawbacks, are not always friendly to the environment and may have an impact on human health [
20]. Therefore, the natural UV-resistant additive, such as, EOs, for effective UV protection is urgently needed.
The components in EOs are mainly secondary metabolites, which are volatile aromatic products extracted from plant species [
21]. Currently, some studies have demonstrated that EOs have biological activities such as antibacterial [22-23], antifungal [24-25], and antiparasitic [
26]. Consequently, various researchers have incorporated EOs into chitosan films to enhance the mechanical and biological properties of chitosan films. Shahbazi et al. explored that the addition of EOs to chitosan films indicated possible antibacterial effect against both gram-positive and gram-negative bacteria [
27]. Wang et al. demonstrated that the synergistic effect of chitosan and cinnamon oil increased the antibacterial activity against
Escherichia coli,
Staphylococcus aureus,
Aspergillus oryzae, and
Staphylococcus spp.,
Staphylococcus aureus,
Aspergillus oryzae, and
Penicillium yangdii, and that the addition of 0.4% cinnamon EOs enhanced the antibacterial performance of chitosan films against a variety of bacteria [28-29]. However, there are few reports on the combination of chestnut flower essential oil (CFEO) with chitosan to prepare composite films. Chestnut flowers are the male inflorescences of chestnut trees, which are long in shape. Chestnut trees are monoecious, and the number of male flowers during flowering is large, far exceeding the pollination needs of female flowers, so a large number of chestnut male flowers cannot be used effectively. As a result, it was generally believed that chestnut flowers contain not only amino acids, proteins, reducing sugars, crude fiber and other nutrients, but flavonoids, volatile oils and other bioactive substances.
Banana is the important and popular fruits due to its good flavor and high nutritional value. However, it is very susceptible to physiological aging and anthracnose infections during storage processes [30-31]. It is highly urgent to explore a simple and effective strategy to increase shelf life of time-sensitive bananas, which are very susceptible to spoilage over time. Herein, in this study, chitosan-chestnut flower extract composite membrane was prepared by using chitosan as the matrix and chestnut flower essential oil as the material. The films were characterized by FITR, XRD, UV, TGA and SEM, and their mechanical properties, antioxidant, antibacterial activities and banana preservation application were also investigated.
2. Materials and Methods
2.1. Materials
Chitosan (CH, degree of deacetylation 80%-90%, MW = 50000 Da) was purchased Shanghai Eon Chemical Technology Co; glycerol and DMSO were supplied by Tianjin Oubokai company; 2,2-diphenyl-1-picrylhydrazyl (DPPH) was supplied by Shanghai Yuanye Biotechnology Co; Acetic acid was purchased from Tianjin Guangfu Technoligy Development company; Escherichia coli (ATCC 25922), Staphylococcus aureus (ATCC 23656) and Calletotrichum musae (ATCC 31244); Castanea mollissima Blume flower, was obtained from Qinglong County, Qinhuangdao City. The chemicals used throughout the experiment were of analytical grade, and the water used for the experiment was deionized water.
2.2. Preparation of CH-CFEO Composite Film
Firstly, the CFEO was extracted from the target using a plant essential oil extraction device (Shunfu Technology Co., Beijing, China) with n-butane as the solvent. Geraniol and menthol are the main components in the CFEO and account for the antibacterial activity from our previously published work [
32]. Then 1.2 g of chitosan was mixed with 1% (v/v) glacial acetic acid, and the temperature of the thermostat stirrer was set to 55°C. After the mixed solution was stirred in the thermostat stirrer for 1 hour, one milliliter of glycerol was added to it and continued to stir for 30 minutes, and the mixed solution was left to stand overnight. The CFEO of different concentrations (6, 8, 10, 20, 40 mg/mL) were dissolved with 1 mL of DMSO, and the film-forming solution was mixed well with the dissolved CFEO (fixed to 10 mL), poured into the mill and dried in an oven at 50°C to obtain the composite film.
2.3. Characterization of Composite Films
2.3.1. Thickness and Mechanical Properties
The thickness of the prepared films was measured using a vernier caliper (Suzhou Guoliang Co., Suzhou, China). The measured values at 5 random locations were recorded and the average value was taken as the final result.
According to the ISO 527-2012 standard method with appropriate modifications, tensile strength (TS) and elongation at break (EB) are tested using a universal material testing machine (INSPEK TABLE100, Germany). Thin film sample strips (50 mm × 20 mm) were stored in the samples at room temperature 23°C, humidity 50% adjusted for 4 days, test type 2, gauge distance 50 mm, speed 5 mm/min. TS was calculated by dividing the maximum force with the initial cross sectional area of the film; EB (%) was calculated by dividing the film elongation at break with the initial gauge length of the specimen. Each sample is tested at least 3 times in parallel (1).
The initial and final length of the film was denoted as L0 and L1, respectively.
2.3.2. Fourier Transformation Infrared Spectroscopy (FT-IR)
The FT-IR spectra of film samples were obtained using a spectrometer (Tensor27, Bruker Corporation, Karlsruhe, Germany). A total of 32 scans were carried out at a spectrum wavenumber range of 400–4000 cm− 1.
2.3.3. Transmittance of the Composite Films
The optical transmittance of the composite films was measured from 200 to 800 nm by a UV–Vis spectrophotometer (U-4100, Hitachi Limited, Tokyo, Japan) [
33].
2.3.4. Atomic Force Microscopy (AFM)
Atomic force microscope (AFM) images were obtained with a Dimension Icon XR atomic force microscope (Bruker, Santa Barbara, CA, USA) working in the air in the Peak Force Tapping (PFT) mode using standard silicon cantilevers (Bruker) with a tip radius below 10 nm. Before measurements, each sample was cut into small pieces and glued to a smooth silicon wafer.
2.3.5. Appearance and Micro-Structure of Films
The appearance of CH/CFEO composite films was captured by a high-resolution camera. The microstructure of the films was invested gated by scanning electron microscope (SEM) (SU 8010, Hitachi Limited, Tokyo, Japan). Film removed of moisture and sputter coated with gold to enhance conductivity. Subsequently, the micro-structure of the films was observed a magnification of 200 × and 500 ×.
2.3.6. X-ray Diffraction (XRD) Analysis
The XRD patterns of the film samples were recorded on a wide-angle X-ray diffractometer (D/max-2500vk/pc, Rigaku Corporation, Tokyo, Japan) under an area detector operating at a voltage of 40 kV and a current of 200 mA using Cu/Kα radiation. The scanning speed was 8° min−1 in the 2θ range from 10 to 80°.
2.3.7. Water Vapor Permeability (WVP)
To evaluate the WVP of the formulated film, we applied the methods of Liu et al. [
34] and Zhang et al.[
35] with some modifications. Film samples were first sealed onto a 15-mL centrifuge tube that contained calcium chloride and then were stored at 20°C in a desiccator together with a beaker filled with distilled water. The film-sealed centrifuge tube was weighed after 24 h and the WVP was calculated as follows(2):
Where W (g) is the bottle weight difference, t (h) is the permeation time; d is the average thickness of the film (mm); A(m2) is the exposed film area; ΔP (Pa) is the vapor pressure difference.
2.3.8. Moisture Content and Water Solubility
Film samples (4 × 4 cm
2) were prepared and weighed (W
S), then dried in an oven at 105°C until a constant weight was reached (W
i)[
36]. The film solubility (MS %) was calculated by using Eq. (3)
Where Wi is the weight of the sample after the drying process (g) and WS is the initial dry weight of the sample (g).
The WS of the film was measured by the method in previously published work [
37]. First, the initial weight of the film was defined as W
1. The film was then immersed in 50 mL of distilled water for 1 h at 30°C. The undissolved film was dried at 105℃ for 24 h and then weighed to obtain the dry weight (W
2). The WS of the prepared films was calculated from equation (4).
2.3.9. Thermogravimetric Analysis (TGA)
TGA of the samples was performed by a thermogravimetric analyzer (STA409PC, PYRIS 1, NETZSCH Gertebau GmbH, Selb, Germany)[
38]. Each film sample (3–5 mg) was sealed in an aluminum plate and heated from 10°C to 800°C at a heating rate of 10°C/min in a nitrogen atmosphere (20 mL/min).
2.3.10. Antioxidant Activity of Composite Films
The antioxidant activity of the films was assessed using a 2,2-biphenyl-1-picrylglycyl (DPPH) radical scavenging method[
39]. The films were cut into 3 cm × 3 cm squares and then placed in a fatty food simulator system (95% alcohol system). Then, 3 mL of the simulated solution containing the active substance was mixed with 1 mL of DPPH ethanol solvent and reacted in the dark for 30 min. The absorbance of the solution was measured by microplate reader (SpectraMax 190, Molecular Devices, Shanghai, China) at 517 nm and the measurements were repeated three times. The scavenging rate of free radicals was determined using equation (5).
where A
0 is the absorbance of the control and A
s is the absorbance of the film sample.
2.4. Antibacterial and Antifungal Activities
2.4.1. Antibacterial Activities
The antibacterial activity of the films against
Staphylococcus aureus and
Escherichia coli was determined using the paper diffusion method reported by Lei et al. with appropriate modifications[
40]. Firstly, 11.75 g of nutrient broth was dissolved in 500 mL of distilled water, simmered with thorough stirring and then sterilized in an autoclave at 121°C, after which the medium was poured in Petri dishes and cooled. Then the
Staphylococcus aureus and
Escherichia coli diluted to a certain concentration (10
5 CFU/ mL) were spread onto the medium respectively. CH blank film with different concentrations of CFEO (6, 8, 10, 20, 40 mg/mL) was spread 7 mm onto the planted medium, and 10% DMSO and 1 μg/mL of levofloxacin were used as negative and positive control. The medium was incubated at 37°C for 24 h, and the inhibition circle of different concentrations of the composite film was measured at the end of the experiment, and the test was measured three times in parallel.
2.4.2. Evaluation of the Effects of CH-CFEO on Calletotrichum musae Mycelial Growth
The antifungal activity of films was determined according to the method published by Yang et al. [
31]. The paper disk diffusion method was used in this study. The effects of CH-CFEO on radial mycelial growth of
C. musae isolates were assessed with a solid media dilution procedure [
41].
C. musae isolates were grown on PDA during 5 days (25 ± 0.5℃), mycelial agar plugs (5 mm diameter) were taken from the margin of the cultures, transferred to the centre of a Petri dish with PDA + CH (50 μg/mL,100 μg/mL) or CFEO (0.03%w/v,0.06%w/v and incubated at 25 ± 0.5℃. PDA without CH or CFEO was tested as a negative. Measurements of orthogonal diameters of fungal colonies were taken after 5 days or up to the negative control Petri dishes were fully covered with fungal mycelia.
Percentage of mycelial growth inhibition (MGI%) was calculated with the equation(6):
where C is the colony diameter in control assay and T is the colony diameter in PDA with CH-CFEO at the examined concentration.
2.5. Effect of Developed Films on Bananas Quality
2.5.1. Sample Preparation
The bananas are placed in sterilized polypropylene boxes, covered with a laminated film, sealed with petroleum jelly. Each group of fruits is weighed regularly and expressed in terms of weight reduction [
42]. Bananas without a composite film were used as a control group.
2.5.2. Weight Loss
To evaluate the moisture loss, the bananas were weighed before (W
0) and after the test (W
1) then we applied the following equation(7).
2.6. Statistical Analysis
All results were performed at least in triplicate, and presented as means ± standard deviations (SD). SPSS 20.0 software (SPSS, Inc., Chicago, IL, U.S.A.) was used to analyze the one-way analysis of variance and significant differences (p < 0.05) among samples using Duncan’s multiple range tests.
3. Results
3.1. Thickness, Water Solubility, Water Content and WVP Rate of Composite Film
Table 1 summarizes the results of the physical and chemical properties of the film. Compared with chitosan control film, the composite film thickness of CFEO increased slightly with different concentrations. When the essential oil concentration reached 40 mg/mL, the thickness of the composite film was 0.12 mm, which may be combined with the alcohols in CFEO with CH, resulting in a tighter structure of the composite membrane [
43], and because chitosan contains a large number of hydroxyl groups, this makes the distance between chitosan molecules narrower and the structure tighter, thus increasing the film thickness [44-45]. For the water solubility of the film, the chitosan control membrane has the largest water solubility, and with the increase of CFEO concentration, the water solubility of the film gradually decreases, and the lowest value is 20.05%, which is about half of the chitosan control film. The reason for the lower water solubility may be due to the hydrophobic nature of CFEO, which interacts less with water molecules, resulting in reduced water solubility. As a result, when CFEO concentration increased, the moisture content of the film underwent a similar change [46-47]. The moisture permeability of the prepared films was observed using the WVP experiment. WVP is a parameter that reflects water vapor adsorption, sorption and diffusion and plays an important role in food packaging [
48]. With the increase of essential oil concentration, the water vapor transmittance of the composite membrane is gradually inducing, especially when the concentration of CFEO is 40 mg/mL, the water vapor transmittance of the composite membrane is 8.13 × 10
-7 (g m
-1h
-1Pa
-1). The low WVP of the food packaging films prevented moisture transfer between the food and its surroundings. Also, the thickness of the film played a vital part in its waterproof performance. The thicker films had lower WVP values because it took longer for water molecules to penetrate the films [
49].
Table 1.
Thickness, water solubility, water content and water vapor transmission rate of composite film.
3.2. FTIR Analysis
The composite films of infrared are shown in
Figure 1a. The infrared spectral peak of the chitosan standard sample presents a wide band with a width of 3375 cm−1, which belongs to OH tensile vibration, overlapping the amino tensile band in the same region. Studies have found that chitosan molecules contain a large amount of free hydroxyl groups and hydrogen, which can easily form intramolecular and intermolecular hydrogen bonds, forming the overall structure of the film 50]. C-H absorption peaks were at 2983 cm−1, and C-O, n-H flexural vibration, C-N tensile and C-O-C band stretching peaks at 1517, 1403, 1264 and 800 cm−1, respectively [
51]. CFEO appears at 2923 cm-1 with a sharp peak, possibly a tensile vibration of C-H on methyl[
52]. After adding CFEO, the crest of the composite membrane did not shift significantly, indicating that there was no chemical reaction between chitosan and CFEO. FT-IR analysis confirmed that hydrogen bonds may have been formed between CH and CFEO, which limited the number of free OH groups interacting with water, resulting in lower WVP values [
49].
3.3. X-ray Diffraction (XRD)
Chitosan blank film, composite membrane diagram of CFEO at different concentrations XRD is shown in Figure 1b. The chitosan blank membrane presents a wide single peak at 2θ about 21°, and its diffraction peak width and height are similar, which can be considered to be an amorphous structure [45, 53]. When CFEO was added, independent and narrow spikes appeared on the XRD map, and with the increase of essential oil concentration, the height of the composite membrane spike increased, which indicated that the addition of CFEO would increase the crystallinity of the composite film, the highest crystallinity was CH-40 (mg/mL), and the lowest was chitosan blank film, which provided favorable evidence for the better mechanical properties and water resistance of the composite membrane.
3.4. TGA
TGA curves presented in
Figure 1c show the films weight loss patterns upon heat treatment. Chitosan blank film has large weight loss at about 100~300°C, indicating poor thermal stability, which is consistent with Zhang's research [
54]. At a concentration of 6 m/mL of CFEO, the first peak of the composite membrane appeared at 90°C, mainly due to the evaporation of water and volatile substances in the composite membrane. With the increase of chestnut flower essential oil concentration, the temperature of the first peak of the composite membrane is correspondingly transferred to a higher value, especially when the essential oil concentration reaches 40 mg/mL, its temperature reaches 154°C. The cause of these changes may be related to hydrophobic compounds in the film that hinder or delay the removal of water vapor and other volatiles [
55], which is consistent with the results of the WS decline previously observed in these films. The second peak varies between 113 and 238°C, which corresponds to the thermal decomposition of hydrogen bonds due to chemical adsorption, as well as the thermal decomposition of less volatile compounds such as amino groups and glycerols of chitosan and organic acids. The third peak observed between 238 and 343°C is primarily the chemical breakdown of the polymer. Overall, after the addition of CFEO, the thermal stability of the membrane is improved, which helps the composite membrane is used at higher temperatures.
3.5. UV
Ultraviolet (UV) radiation from the solar spectrum has a ubiquitous harmful impact on human health and other biological systems [
56]. UV will induce the spoilage of food products. Developing UV-blocking packaging materials have been gradually gaining attention [
57].
Figure 1d studied the UV and visible light blocking of the thin film at 200-800 nm. It can be seen from the figure that the chitosan blank film has the highest transmittance and has low UV blocking performance. After adding essential oils, the transmittance is less than 20% in the wavelength range of 100-400 nanometers (ultraviolet region), indicating that they are highly UV-blocking materials. Similar findings have been reported in previous articles [58-59]. Especially, Ren et al.[
60] prepared zein/chitosan/eugenol/curcumin active films with enhanced anti-UV ability. In the range of visible light region, especially at 680 nm, the visible light transmittance of the control film is higher than that of the composite film, and when the concentration of CFEO increases sequentially, the transmittance of the composite film gradually decreases, and when the concentration of essential oil is 40 mg/mL, the transmittance is about 17%, which may be due to the opaque appearance of the composite film causing light scattering, hindering normal light transmission. These results suggest that the film after the addition of chestnut flower essential oil can prevent the loss of nutrients and odor caused by direct exposure of certain foods to ultraviolet light [
61]. Moreover, there were some other reports presenting the similar phenomena apart from this work. Roy and Rhim developed a bioactive binary composite film based on gelatin/chitosan incorporated with cinnamon EOs. The results showed that this film had good UV blocking capacity [
62].
3.6. The Mechanical Properties of Composite Film
The mechanical properties of packaging materials are important parameters for judging the quality of packaging materials, mainly including tensile strength (TS) and elongation at break (EB) [
63]. Tensile strength refers to the stress of the material to produce the maximum uniform plastic deformation, and elongation at break is an indicator of the toughness and elasticity of the material. From the
Figure 2, we can see that as the concentration of CFEO increases, the tensile strength of the film gradually decreases. The tensile strength of chitosan blank film is 7.96 MPa, and when the essential oil concentration is 6 mg/ml (w/v), the tensile strength of the film is 6.66 Mpa, and the decrease is not obvious. With the further increase of CFEO concentration, the tensile strength of the film decreases, especially when the essential oil concentration is 40 mg/ml, the tensile strength of the film drops to 0.84 MPa, which is about 10 mg/ml of the chitosan blank film, which may be due to the cross-linking of some functional groups in chestnut flower essential oil with the functional groups in chitosan, weakening the interaction between the two molecules, resulting in a decrease in tensile strength. On the other hand, the reason may be that the size of CFEO affects the combination of the two, resulting in pores inside the film (which can be verified from the scanning electron microscope cross-section), so that the tensile strength of the film decreases. For the elongation at break of the film, similar results to tensile strength appeared, but it is worth noting that when the chestnut flower essential oil concentration was 8 mg/ml, the elongation at break of the film was 23.93%, which was slightly enhanced compared to the essential oil concentration of 6 mg/ml (22.82%).
3.7. SEM and AFM of Prepared Film
The uniformity and network structure of the film-forming matrix were analyzed by SEM morphology (
Figure 3). After adding different concentrations of chestnut flower essential oil, the surface and cross-sectional SEM micrograph of the film are shown in the figure. From the scanning electron microscopy of the film, it can be seen that compared with the chitosan blank film, the surface and cross-sectional structure morphology of the film after adding chestnut flower essential oil have certain differences. The surface of the chitosan blank film is smooth and flat, and there are no holes, pores and cracks on the cross-section of the film. With the addition of chestnut flower essential oil, bulges appear on the surface of the film, forming small bulges one by one, probably due to the high hydrophobicity of chestnut flower essential oil. When the concentration of chestnut flower essential oil was 6 mg/ml, there were no obvious holes and cracks in the cross-section of the film, indicating that the low concentration of chestnut flower essential oil could be evenly distributed in the membrane matrix, with strong interaction and good compatibility of each film-forming matrix. In addition, the cross-sectional structure morphology of the higher concentration chitosan-chestnut flower essential oil film did not appear more pores or cavities, but only folds appeared, indicating that the film-forming solution had good compatibility with chestnut flower essential oil, resulting in its structure becoming denser, which can also be used to explain the gradual decrease in the water vapor transmittance of the film with the increase of essential oil concentration. On the other hand, the inclusion of the CFEO resulted in greater roughness as well as the formation of aggregates (
Figure 3I–VI). The reason for such behavior can be seen in the high hydrophobicity of the CFEO, which when introduced into the polymer solution tends to agglomerate, which results in visible cracks in the surface and cross-section images [
64]. However, the differences between samples, which was showed in
Figure 3IV, V and VI, may result from the differences in water content of the CH-CFEO complexes, based on the water content (WC) results (
Table 1). Moreover, the differences between samples in
Figure 3II and III, may result from uneven drying of the film.
3.8. DPPH Assay for Free Radical Scavenging
The DPPH free radical-scavenging percentage was used to determine the antioxidant activity of the film. The quenching and decolorization of DPPH free radicals result in their reduction to the yellow diphenylpicryl hydrazine with a corresponding reduction in absorbance value [
64]. The DPPH radical-scavenging capacity of the active composite films was determined (
Figure 4). It was found that the scavenging capacity of the composite membrane increased as the CFEO content increased. The test results showed that with the increase of CFEO concentration, the antioxidant capacity of the composite membrane gradually increased, especially when the concentration of essential oil reached 40 mg/mL, the antioxidant value of the composite membrane reached the highest. The reason may be that the improved active surface area and internal structure of the CH active film was uniform and dense, with high stability, leading to continuous interaction and cooperation between chitosan-and chestnut flower essential oil and a consequent superior ability to scavenge DPPH free radicals.
3.9. The antibacterial and Antifungal Activities of Film
The antibacterial activity of CH-CK (with zero CFEO)、CH-6 (with 6 mg/ml CFEO)、CH-8 (with 8 mg/ml CFEO), CH-10 (with 10 mg/ml CFEO), CH-20 (with 20 mg/ml CFEO) and CH-40 (withs 40 mg/mL CFEO) film was tested against gram-negative (
E. coli) and gram-positive (
S. aureus) bacteria.
Figure 5 showed the antibacterial effect of two bacteria exposed to the films. Compared with the chitosan blank membrane, when the concentration of chestnut flowers reaches 10 mg/mL, the film still has high bacteriostatic activity against
Staphylococcus aureus. However, with the further increase of chestnut flower concentration, the bacteriostatic effect of the film on
Staphylococcus aureus declines, which may be due to the fact that when the concentration of CFEO increases, chitosan and the groups in chestnut flower essential oil are more firmly combined, resulting in the antibacterial components in the essential oil are difficult to release, and the bacteriostatic activity is correspondingly reduced. It is worth noting that compared with the bacteriostatic effect of
Staphylococcus aureus, the antibacterial effect of CH-CFEO complex membrane on
Escherichia coli is significantly lower than that of
Staphylococcus aureus. The main reason is that
E. coli belong to gram-negative bacteria, they have a hard protective shell, and when their cell walls are disturbed, gram-negative bacteria can enhance their resistance by changing their hydrophobic properties or by changing their outer membrane through mutations in pore proteins. In the case of
Staphylococcus aureus, although they have a thicker peptidoglycan layer, they are more vulnerable to attack from the outside world due to the lack of an outer membrane. This is also the reason why the two show different antibacterial effects on the composite film. Therefore, this film exhibit increased protective barriers, possibly as a result of its antibacterial activity.
All tested CH-CFEO concentrations caused mycelial growth inhibition toward
C. musae isolates (
Figure 6 and
Table 2). CH (50 μg/mL) and CFEO (300, 600 μg/m L) caused MGI% in the range of 12.19 to 48.85%, respectively. Moreover, the concentration of CH (100 μg/mL) and CFEO (300, 600 μg/m L) caused MGI% in the range of 23.65 to 59.88%. These data indicate that the combinations of the lowest tested combined concentrations of CH (100mg/mL) and CFEO (300, 600 μg/mL) had overall higher efficacy to inhibit the targe. The antifungal properties of CH have been commonly associated with the interactions between positively charged CH molecules and negatively charged fungal cell membranes, causing alterations in membrane permeability and loss of electrolites and orther intracellular constituents inportant for fungal growth and survival [65-67]. CFEO (300, 600 µg/mL) also exerted inhibitory effects on the mycelial growth of all tested
C. musae isolates. The results of these early investigations also revealed overall that the inhibitory effects on fungal growth increased when the EOs concentrations increase [68-70]. Lundgr et al. investigated that the antifungal effects of
Conyza bonariensis (L.) Cronquist essential oil (CBCO) against pathogenic
Colletotrichum musae. Coatings with CBEO (0.4-1 μl ml
-1 ) reduced the anthracnose development in banana artificially contaminated with
C. musae during storage [
71].
3.10. Effects on Bananas Preservation
Figure 7 shows the effect of the composite films on the freshness of the bananas. The Bare group can clearly demonstrate that the bananas were significantly darkened and rotted on the sixth day. Meanwhile, for the group with CH-CK film, the CH-6、CH-8、CH-10 and CH-20 mg/mL film the significant spotting and darkening could also be observed. On the contrary, for the CH-40 mg/mL film, the least darkening and spoiling of bananas were observed, indicating a superior freshness preservation effect.
Figure 7 shows the relationship between the weight loss rate of bananas and time, the weight loss rate of the composite films was close in the first day, and the lowest weight loss rate of CH-40 mg/mL film could be observed on the 6th day. This could be explained by the relatively low water permeability and blocking oxygen capability of the CH-40 mg/mL film, which provides multiple protective functions to reduce the weight loss of fruits and thus extending the shelf life of bananas. For the preservation effect of bananas, with the increase of CFEO concentration, the film's UV resistance is also increasing, especially when the concentration of chestnut flower essential oil reaches 40 mg/mL, the film's ultraviolet resistance reaches the highest, which can be verified from the apparent form of bananas after 6 days, so that the film of chestnut flower essential oil of 40mg/ml can significantly extend the shelf life of bananas.
4. Conclusions
In summary, the CH-CFEO packaging film was prepared by casting method. TG tests have shown that the addition of CFEO improves the heat resistance of the film. Antibacterial and antioxidant experiments have also shown that the introduction of CFEO further improves the antibacterial, antioxidant properties of the film. Moreover, these films can prevent UV-induced spoilage of food and have the potential to be applied as food packaging. CH-40 mg/mL film can significantly extend the shelf life of bananas due to its low water vapor permeability and effective antibacterial and oxidation resistance. Therefore, composite films have important prospects as an active packaging material with a variety of fruit preservation and protection functions, which also provides an innovative example for the conversion of readily available natural biopolymers into profitable products that replace synthetic plastics and to meet the use of packaging film scenarios.
Author Contributions
Conceptualization, Resources, Methodology, Data Curation, Writing—Original Draft: Y.L.; Methodology, Investigation, Data Curation, Project Administration: B.D.; Methodology, Investigation, Validation: J.Z.; Methodology, Validation: F.P.; Methodology, Data curation, Validation: K.N; Data curation, Methodology, Validation: W.H.; Methodology, Investigation: Y.Y.
Data Availability Statement
We encourage all authors of articles published in MDPI journals to share their research data. In this section, please provide details regarding where data supporting reported results can be found, including links to publicly archived datasets analyzed or generated during the study. Where no new data were created, or where data is unavailable due to privacy or ethical restrictions, a statement is still required. Suggested Data Availability Statements are available in section “MDPI Research Data Policies” at
https://www.mdpi.com/ethics.
Acknowledgments
This work was technically supported by Analysis and Testing Center, Hebei Normal University of Science and Technology.
Conflicts of Interest
We declare that the work has not been published elsewhere or considered other journals. The manuscript is authorized by all authors to be submitted to International Journal of Biological Macromolecules. The authors declare that they have no known competing financial interests or personal relationships that could affect the work reported in this paper.
References
- Huang, K.; Wang,Y. Recent applications of regenerated cellulose films and hydrogels in food packaging. Curr. Opin. Food Sci. 2022, 43, 7–17. [Google Scholar] [CrossRef]
- Liu, J.; Liu, S.; Chen, Y.; Zhang, L.; Kan, J.; Jin, C. Physical, mechanical and antioxidant properties of chitosan films grafted with different hydroxybenzoic acids. Food Hydrocoll. 2017, 71, 176–186. [Google Scholar] [CrossRef]
- Hamann, D.; Puton, B.M.S.; Colet, R.; Steffens, J.; Ceni, G.C.; Cansian, R.L.; TBackes, G. Active edible films for application in meat products. Res. Soc. Dev. 2021, 10, 7. [Google Scholar]
- Najwa, I.; Guerrero, P.; Caba, K.; Hanani,Z. Physical and antioxidant properties of starch/gelatin films incorporated with Garcinia atroviridis leaves. Food Packag. Shelf Life 2020, 26, 100583. [Google Scholar] [CrossRef]
- Rahman, P.M.; Mujeeb, V.M.A.; Muraleedharan, K. Flexible chitosan-nano ZnO antimicrobial pouches as a new material for extending the shelf life of raw meat. Int. J. Biol. Macromol. 2017, 97, 382–391. [Google Scholar] [CrossRef]
- Dutta, P.K.; Tripathi, S.; Mehrotra, G.K.; Dutta, J. Perspectives for chitosan based antimicrobial films in food applications. Food Chem. 2009, 114, 1173–1182. [Google Scholar] [CrossRef]
- Espitia, P.J.P.; Du, W.X.; Avena-Bustillos, R.D.J.; Soares, N.D.F.F.; Mchugh, T.H. Edible films from pectin: physical-mechanical and antimicrobial properties-a review. Food Hydrocoll. 2014, 35, 287–296. [Google Scholar] [CrossRef]
- Zhang, X.; Ismail, B.B.; Cheng, H.; Jin, T.Z.; Qian, M.; Arabi, S.A.; Liu, D.; Guo, M. Emerging chitosan-essential oil films and coatings for food preservation - A review of advances and applications. Carbohydr Polym. 2021, 273, 118616. [Google Scholar] [CrossRef]
- Dash, M.; Chiellini, F.; Ottenbrite, R.M.; Chiellini, E. Chitosan-A versatile semi-synthetic polymer in biomedical applications. Prog Polym Sci. 2011, 36, 981–1014. [Google Scholar] [CrossRef]
- Cavallaro, G.; Micciulla, S.; Chiappisi, L.; Lazzara, G. Chitosan-based smart hybrid materials: a physico-chemical perspective. J Mater Chem B 2021, 9, 94–611. [Google Scholar] [CrossRef]
- Dai, W.; Zhou, L.; Gu, S.; Wang, W.; Xu, Z.; Zhou, X.; Ding, Y. Preparation and characterization of chitosan films incorporating epigallocatechin gallate: Microstructure, physicochemical, and bioactive properties. Int J Biol Macromol. 2022, 211, 729–740. [Google Scholar] [CrossRef] [PubMed]
- Kumar, S.; Mukherjee, A.; Dutta, J. Chitosan based nanocomposite films and coatings: Emerging antimicrobial food packaging alternatives. Trends Food Sci Technol. 2020, 97, 196–209. [Google Scholar] [CrossRef]
- Lisuzzo, L.; Cavallaro, G.; Milioto, S.; Lazzara, G. Layered composite based on halloysite and natural polymers: A carrier for the pH controlled release of drugs. New J. Chem. 2019, 43, 10887–10893. [Google Scholar] [CrossRef]
- Ashrafifi, A.; Jokar, M.; Nafchi, A.M. Preparation and characterization of biocomposite film based on chitosan and kombucha tea as active food packaging. Int J Biol Macromol. 2018, 108, 444–454. [Google Scholar] [CrossRef] [PubMed]
- Dutta, P.K.; Tripathi, S.; Mehrotra, G.K.; Dutta, J. Perspectives for chitosan based antimicrobial films in food applications. Food Chem. 2009, 114, 114,1173–11182. [Google Scholar] [CrossRef]
- Azeredo, H.M.C.; Morrugares-Carmona, R.; Wellner,N. ; Cross,K.; Bajka, B.; Waldron, K.W.Development of pectin films with pomegranate juice and citric acid. Food Chem. 2016, 198, 101–106. [Google Scholar] [CrossRef] [PubMed]
- Babaei-Ghazvini, A.; Shahabi-Ghahfarrokhi, I.; Goudarzi,V. Preparation of UV protective starch/kefiran/ZnO nanocomposite as a packaging film: Characterization. Food Packag Shelf Life. 2018, 16, 103–111. [Google Scholar] [CrossRef]
- Chang, X.; Hou, Y.; Liu, Q.; Hu, Z.; Xie, Q.; Shan, Y.; Li, G.; Ding, S. Physicochemical and antimicrobial properties of chitosan composite films incorporated with glycerol monolaurate and nano-TiO2. Food Hydrocolloids. 2021, 119, 106846. [Google Scholar] [CrossRef]
- Zhao, H.; Zhu, Y.; Zhang,H. ; Ren, H.; Zhai, H. UV-blocking composite films containing hydrophilized spruce kraft lignin and nanocellulose: Fabrication and performance evaluation. Int J Biol Macromol. 2023, 242, 124946. [Google Scholar] [CrossRef]
- Wang, D.; Guan, C.; Sun, L.; Zhang, Q.; Pan, S.; Chen, H. Improvement of the UV-resistance capability of fish gelatin-oxidized starch film via inserting mycosporine-like amino acids. J Sci Food Agric. 2023, 103, 5087–5095. [Google Scholar] [CrossRef] [PubMed]
- Elshafifie, H.S.; Camele, I. An overview of the biological effects of some mediterranean essential oils on human health. BioMed Res. Int. 2017, 9268468. [Google Scholar] [CrossRef] [PubMed]
- Mourey, A.; Canillac, N. Anti-listeria monocytogenes activity of essential oils components of conifers. Food Control 2002, 13, 289–292. [Google Scholar] [CrossRef]
- Burt, S.A.; Reinders,R.D.Antibacterial activity of selected plant essential oils against Escherichia coli O157:H7. Lett Appl Microbiol. 2003, 36, 162–167. [CrossRef]
- Božovi´c, M.; Garzoli, S.; Sabatino, M.; Pepi, F.; Baldisserotto, A.; Andreotti, E.; Romagnoli, C.; Mai, A.; Manfredini, S.; Ragno, R. Essential oil extraction, chemical analysis and anti-candida activity of Calamintha nepeta (L.) Savi subsp. glandulosa (Req.) ball-new approaches. Molecules 2017, 22, 203. [Google Scholar] [CrossRef] [PubMed]
- Bae, Y.S.; Rhee, M. S. Short-term antifungal treatments of caprylic acid with carvacrol or thymol induce synergistic 6-log reduction of pathogenic candida albicans by cell membrane disruption and flux pump inhibition. Cell. Physiol. Biochem. 2019, 53, 285–300. [Google Scholar] [PubMed]
- Anthony, J. P.; Fyfe, L.; Smith, H. Plant active components–A resource for antiparasitic agents? Trends Parasitol. 2005, 21, 462–468. [Google Scholar] [CrossRef]
- Shahbazi, Y. The properties of chitosan and gelatin films incorporated with ethanolic red grape seed extract and Ziziphora clinopodioides essential oil as biodegradable materials for active food packaging. Int J Biol Macromol. 2017, 99, 746–753. [Google Scholar] [CrossRef] [PubMed]
- Wang, L.; Liu, F.; Jiang, Y.; Chai, Z.; Li, P.; Cheng, Y.; Jing, H.; Leng, X. Synergistic antimicrobial activities of natural essential oils with chitosan films. J Agric Food Chem. 2011, 59, 12411–12419. [Google Scholar] [CrossRef] [PubMed]
- Ojagh, S.M.; Rezaei, M.; Razavi, S.H.; Hosseini, S.M.H. Development and evaluation of a novel biodegradable film made from chitosan and cinnamon essential oil with low affinity toward water. Food Chem. 2010, 122, 166. [Google Scholar] [CrossRef]
- Vilaplana, R.; PazminO, L.; Valencia-Chamorro,S. Control of anthracnose, caused by Colletotrichum musae, on postharvest organic banana by thyme oil. Postharvest Biol. Technol. 2018, 138, 56–63. [Google Scholar] [CrossRef]
- Yang, Z.; Li, M.; Zhai, X.; Zhao, L.; Tahir, H. E.; Shi, J.; Zou, X.; Huang, X.; Li, Z.; Xiao, J. Development and characterization of sodium alginate/tea tree essential oil nanoemulsion active film containing TiO2 nanoparticles for banana packaging. Int J Biol Macromol. 2022, 213, 145–154. [Google Scholar] [CrossRef] [PubMed]
- Liu, J.F.; Yang, Y.D.; Du, B.; Zhang, J.W.; Zhou, Y. Supercritical fluid extraction and GC-MS analysis of volatile oil from Chinese chestnut flower. J. Hebei Norm. Univ. Sci. Technol. 2016, 30, 26–29. [Google Scholar]
- Liu, W.; Kang, S.; Zhang, Q.; Chen, S.; Yang, Q.; Yan, B. Self-assembly fabrication of chitosan-tannic acid/MXene composite film with excellent antibacterial and antioxidant properties for fruit preservation. Food chem. 2023, 410, 135405. [Google Scholar] [CrossRef] [PubMed]
- Zhang, L.; Zhang, Z.; Chen, Y.; Ma, X.; Xia, M. Chitosan and procyanidin composite films with high antioxidant activity and pH responsivity for cheese packaging. Food Chem. 2021, 338, 128013. [Google Scholar] [CrossRef] [PubMed]
- Liu, J.; Liu, S.; Wu, Q.; Gu, Y.; Kan, J.; Jin, C. Effect of protocatechuic acid incorporation on the physical, mechanical, structural and antioxidant properties of chitosan film. Food Hydrocolloids. 2017, 73, 90–100. [Google Scholar] [CrossRef]
- Zhang, X.; Liu, Y.; Yong, H.; Qin, Y.; Liu, J.; Liu, J. Development of multifunctional food packaging films based on chitosan, TiO2 nanoparticles and anthocyanin-rich black plum peel extract. Food Hydrocolloids. 2019, 94, 80–92. [Google Scholar] [CrossRef]
- Da Silva, D.C.; Lopes, I.A.; Da Silva, L.J.S.; Lima, M.F.; Barros Filho,A. K.D.; VillaV´elez, H.A.; Santana, A.A. Physical properties of films based on pectin and babassu coconut mesocarp. Int J Biol Macromol. 2019, 130, 419–428. [Google Scholar] [CrossRef] [PubMed]
- Al-Maqtari, Q.A.S.; Al-Gheethi, A.A.S.; Ghaleb, A.D.A.; Mahdi, A.; Al-Ansi,W. A.; Noman, E.A.; Al-Adeeb, A.K.O.; Odjo; Du, Y.H.; Wei, M.P.; Yao,W,R. Fabrication and characterization of chitosan/gelatin films loaded with microcapsules of Pulicaria jaubertii extract. Food Hydrocolloids 2022, 129, 107624. [Google Scholar] [CrossRef]
- Zhang, L.; Zhang, Z.; Chen, Y.; Ma, X.; Xia, M. Chitosan and procyanidin composite films with high antioxidant activity and pH responsivity for cheese packaging. Food Chem. 2021, 338, 128013. [Google Scholar] [CrossRef]
- Alam, T.; Asif, S.; Ayaz, S.; Rehman, H.; Sana, A.; Alam, S.; Qamar, F.; Naveed, S.; Ghi, A.O. Total phenolic content and total flavonoid content of embelia ribes by radical scavenging activity. Lat. Am. J. Pharm. 2019, 38, 1467–1471. [Google Scholar]
- Dos Passos Braga, S.; Lundgren, G.A.; Macedo, S.A.; Tavares, J.F.; Dos Santos Vieira, W.A.; Câmara, M.P.S.; de Souza, E.L. Application of coatings formed by chitosan and Mentha essential oils to control anthracnose caused by Colletotrichum gloesporioides and C. brevisporum in papaya (Carica papaya L.) fruit. Int J Biol Macromol. 2019, 139, 631–639. [Google Scholar] [CrossRef] [PubMed]
- Lei, Y.; Wu, H.; Jiao, C.; Jiang, Y.; Liu, R.; Xiao, D.; Lu, J.; Zhang, Z.; Shen, G.; Li, S. Investigation of the structural and physical properties, antioxidant and antimicrobial activity of pectinkonjac glucomannan composite edible films incorporated with tea polyphenol. Food Hydrocolloids. 2019, 94, 94,128–135. [Google Scholar] [CrossRef]
- Chen, Y.; Li, Y.; Qin, S.; Han, S.; Qi, H. Antimicrobial, UV blocking, waterresistant and degradable coatings and packaging films based on wheat gluten and lignocellulose for food preservation. Compos 2022, 238, 109868. [Google Scholar]
- Zhang, Y.Y.; Yang, Y.; Tang, K.; Hu, X.; Zou, G. L. Physicochemical characterization and antioxidant activity of quercetin-loaded chitosan nanoparticles. J Appl Polym Sci. 2008, 107, 107,891–897. [Google Scholar] [CrossRef]
- Halasz, K.; Csóka, L. Black chokeberry (Aronia melanocarpa) pomace extract immobilized in chitosan for colorimetric pH indicator film application. Food Packag Shelf Life 2018, 16, 185–193. [Google Scholar] [CrossRef]
- Wang, L.Y.; Guo, H.Y.; Wang, J.; Jiang, G.C.; Du, F.H.; Liu, X.J. Effects of Herba Lophatheri extract on the physicochemical properties and biological activities of the chitosan film. Int J Biol Macromol. 2019, 133, 51–57. [Google Scholar] [CrossRef] [PubMed]
- Uranga, J.; Puertas, A.I.; Etxabide, A.; Dueñas, M.T.; Guerrero, P.; de la Caba,K. Citric acid incorporated fish gelatin/chitosan composite films. Food Hydrocolloids. 2019, 86, 95–103. [Google Scholar] [CrossRef]
- Rui, L.; Min, H.X.; Bing, H.; Li, Z.; Dan, Y.Y.; Xiao, X.Z. A comparative study on chitosan/gelatin composite films with conjugated or incorporated gallic acid. Carbohydr Polym. 2017, 173, 473–481. [Google Scholar] [CrossRef]
- Díaz-Montes, E.; Ya´nez-Fernandez, J.; Castro-Munoz, R. Dextran/chitosan blend film fabrication for bio-packaging of mushrooms (Agaricus bisporus). J Food Process Preserv. 2021, 45, e15489. [Google Scholar] [CrossRef]
- Fabra, M.J.; Falc´o, I.; Randazzo, W.; anchez, G.; S´opez-Rubio, A. L. Antiviral and antioxidant properties of active alginate edible films containing phenolic extracts. Food Hydrocolloids. 2018, 81, 96–103. [Google Scholar] [CrossRef]
- Lawrie, G.; Keen, I.; Drew, B.; Chandler-Temple, Rintoul, A. L.; Fredericks, P. ;Grøndahl, L. Interactions between alginate and chitosan biopolymers characterized using FTIR and XPS. Biomacromolecules 2007, 8, 2533–2541. [Google Scholar] [CrossRef]
- Qiao, C.; Ma, X.; Zhang, J.; Yao, J. Molecular interactions in gelatin/chitosan composite films. Food Chem. 2017, 235, 45–50. [Google Scholar] [CrossRef] [PubMed]
- Raphaël, K.J.; Meimandipoour, A. Antimicrobial activity of chitosan film forming solution enriched with essential oils; an in Vitro Assay. Iran J Biotechnol. 2017, 15, 111–119. [Google Scholar] [PubMed]
- Wang, L.Y.; Guo, H.Y.; Wang, J.; Jiang, G.C.; Du, F.H.; Liu, X.J. Effects of Herba Lophatheri extract on the physicochemical properties and biological activities of the chitosan film. Int J Biol Macromol. 2019, 133, 51–57. [Google Scholar] [CrossRef]
- Zhang, L.; Li, K.; Yu, D.; Regenstein, J.M.; Dong, J.; Chen, W.; Xia, W. Chitosan/zein bilayer films with one-way water barrier characteristic: Physical, structural and thermal properties. Int J Biol Macromol. 2022, 200, 378–387. [Google Scholar] [CrossRef] [PubMed]
- Li, Y.; Chen, Y.; Wu, Q.; Huang, J.; Zhao, Y.; Li, Q.; Wang, S. Improved Hydrophobic, UV Barrier and Antibacterial Properties of Multifunctional PVA Nanocomposite Films Reinforced with Modified Lignin Contained Cellulose Nanofibers. Polymers 2022, 14, 1705. [Google Scholar] [CrossRef]
- Dou, J.; Vuorinen, T.; Koivula, H.; Forsman, N.; Sipponen, M.; Hietala, S. Self-standing lignin-containing willow bark nanocellulose films for oxygen blocking and UV shielding. ACS Appl. Nano Mater. 2021, 4, 2921–2929. [Google Scholar] [CrossRef]
- Cao, T.L.; Song, K.B. Effects of gum karaya addition on the characteristics of loquat seed starch films containing oregano essential oil. Food Hydrocolloids. 2019, 97, 105198. [Google Scholar] [CrossRef]
- Riaz, A.; Lei, S.; Akhtar, H.M.S.; Wan, P.; Chen, D.; Jabbar, S.; Abid, M.; Hashim, M.M.; Zeng, X. Preparation and characterization of chitosan-based antimicrobial active food packaging film incorporated with apple peel polyphenols. Int J Biol Macromol. 2018, 114, 547–555. [Google Scholar] [CrossRef] [PubMed]
- Ren, M.; Cai, Z.; Chen, L.; Wa, H.; Zhang, L.; Wang, Y.; Yu, X.; Zhou, C. Preparation of zein/chitosan/eugenol/curcumin active films for blueberry preservation. Int J Biol Macromol. 2022, 223, 1054–1066. [Google Scholar] [CrossRef]
- Tessaro, L.; Luciano, C.G.; Quinta Barbosa Bittante, A.M.; Lourenço, R.V.; MartelliTosi, M.; Jos´e do Amaral Sobral, P. Gelatin and/or chitosan-based films activated with “Pitanga” (Eugenia uniflora L.) leaf hydroethanolic extract encapsulated in double emulsion. Food Hydrocolloids. 2021, 113, 106523. [Google Scholar] [CrossRef]
- Roy, S.; Rhim, J.W. Fabrication of bioactive binary composite film based on gelatin/chitosan incorporated with cinnamon essential oil and rutin. Colloids Surf B Biointerfaces. 2021, 204, 111830. [Google Scholar] [CrossRef]
- Qin, Y.; Liu, Y.; Yuan, L.; Yong, H.; Liu, J. Preparation and characterization of antioxidant, antimicrobial and pH-sensitive films based on chitosan, silver nanoparticles and purple corn extract. Food Hydrocolloids. 2019, 96, 102–111. [Google Scholar] [CrossRef]
- Benbettaieb, N.; Tanner, C.; Cayot, P.; Karbowiak, T.; Debeaufort, F. Impact of functional properties and release kinetics on antioxidant activity of biopolymer active films and coatings. Food Chem. 2018, 242, 369–377. [Google Scholar] [CrossRef] [PubMed]
- Guerra, I.C.D.; de Oliveira, P.D.L.; de Souza Pontes, A.L.; Lúcio, A.S.S.C.; Tavares, J.F.; Barbosa-Filho, J.M.; Madruga, M.S.; de Souza, E.L. Coatings comprising chitosan and Mentha piperita L. or Mentha × villosa Huds essential oils to prevent common postharvest mold infections and maintain the quality of cherry tomato fruit. Int J Food Microbiol. 2015, 214, 168–178. [Google Scholar] [CrossRef] [PubMed]
- de Oliveira, K.Á.R.; Berger, L.R.R.; de Araújo, S.A.; Câmara, M.P.S.; de Souza, E.L. Synergistic mixtures of chitosan and Mentha piperita L. essential oil to inhibit Colletotrichum species and anthracnose development in mango cultivar Tommy Atkins. Food Microbiol. 2017, 66, 96–103. [Google Scholar] [CrossRef] [PubMed]
- Munhuweyi, K.; Caleb, O.J.; Lennox, C.L.; van Reenen, A.J.; Opara, U.L. In vitro and in vivo antifungal activity of chitosan-essential oils against pomegranate fruit pathogens. Postharvest Biol. Technol. 2017, 129, 9–22. [Google Scholar] [CrossRef]
- Santos, N.S.T.D.; Athayde Aguiar, A.J.A.; Oliveira, C.E.V.D. Efficacy of the application of a coating composed of chitosan and Origanum vulgare L. essential oil to control Rhizopus stolonifer and Aspergillus niger in grapes (Vitis labrusca L.). Food Microbiol. 2012; 32. [Google Scholar]
- Monzón-Ortega, K.; Salvador-Figueroa, M.; Gálvez-López, D.; Rosas-Quijano, R.; Ovando-Medina, I.; Vázquez-Ovando, A. Characterization of Aloe vera-chitosan composite films and their use for reducing the disease caused by fungi in papaya Maradol. J Food Sci Technol. 2018, 55, 4747–4757. [Google Scholar] [CrossRef] [PubMed]
- Xu, D.; Qin, H.R.; Ren, D. Prolonged preservation of tangerine fruits using chitosan/montmorillonite composite coating. Postharvest Biol. Technol. 2018, 143, 50–57. [Google Scholar] [CrossRef]
- Lundgren, G.A.; Braga, S.D.P.; de Albuquerque, T.M.R.; Árabe Rimá de Oliveira, K.; Tavares, J.F.; Vieira, W.A.D.S.; Câmara, M.P.S.; de Souza, E.L. Antifungal effects of Conyza bonariensis (L.) Cronquist essential oil against pathogenic Colletotrichum musae and its incorporation in gum Arabic coating to reduce anthracnose development in banana during storage. J Appl Microbiol. 2022, 132, 547–561. [Google Scholar] [CrossRef]
|
Disclaimer/Publisher’s Note: The statements, opinions and data contained in all publications are solely those of the individual author(s) and contributor(s) and not of MDPI and/or the editor(s). MDPI and/or the editor(s) disclaim responsibility for any injury to people or property resulting from any ideas, methods, instructions or products referred to in the content. |
© 2024 by the authors. Licensee MDPI, Basel, Switzerland. This article is an open access article distributed under the terms and conditions of the Creative Commons Attribution (CC BY) license (http://creativecommons.org/licenses/by/4.0/).